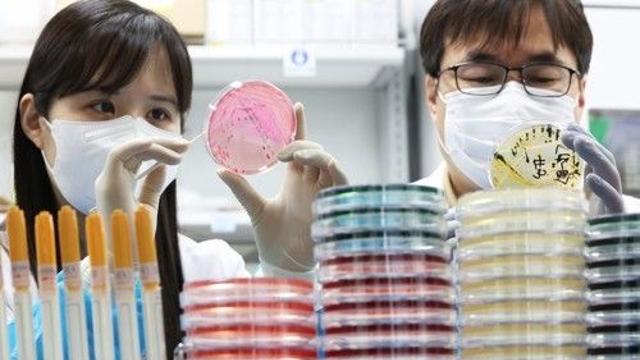

![[플레이브] 노아의 무물타임 몰아보기???? #스포요정 #유출요정 #무물 #플레이브 #plave](https://i.ytimg.com/vi/504oK_TkIHc/mqdefault.jpg)
[플레이브] 노아의 무물타임 몰아보기???? #스포요정 #유출요정 #무물 #플레이브 #plave
#플레이브
2026.02.10
![[플레이브] 노아의 무물타임 몰아보기???? #스포요정 #유출요정 #무물 #플레이브 #plave](https://i.ytimg.com/vi/504oK_TkIHc/mqdefault.jpg)
#플레이브
2026.02.10

#플레이브
2026.02.10

#플레이브
2026.02.10

#플레이브
2026.02.10

#시크릿넘버
2026.02.10

#미야오
2026.02.10

#유니스
2026.02.10
![[아이브] 오랜만에 랩 제대로 쫀득하게 말아준 감성즈 ???? #ive #bangbang](https://i.ytimg.com/vi/sKuMSLHdpc4/mqdefault.jpg)
#IVE
2026.02.09
 |
고창군자원봉사센터, 추석 명절 꾸러미 온기나눔 실천중도일보 2025.10.03 |
 |
고창군, ‘넓적부리도요’ 10월 고창갯벌 이달의 새 선정중도일보 2025.10.03 |
 |
고창의용소방대연합회, 소방기술경연대회 개최중도일보 2025.10.03 |
 |
정읍시, 내수면 양식장 합동 안전점검중도일보 2025.10.03 |
 |
"차이나 아웃"…개천절 서울 곳곳서 열린 '반중 집회'모두서치 2025.10.03 |
 |
추석 밥상 주인공 달걀…'갈색 vs 흰색' 영양소 다른가요?모두서치 2025.10.03 |
 |
농식품부 “소고기 부정유통 강력하게 엄단할 것”직썰 2025.10.03 |
 |
한학자, 내일 또 특검 불출석…"건강상 이유" 사유서 제출연합뉴스 2025.10.03 |
 |
비싸도 산다...1kg에 150만원까지 올랐는데 없어서 못 산다는 '이것'위키트리 2025.10.03 |
![[영상] '하늘을 달리다' 춘천연합마라톤 4천833명 출발!…](https://images-cdn.newspic.kr/thumb1/2025/10/03/0ee30534-b7a2-4d15-87ac-7b99aa4851cc.jpg) |
[영상] '하늘을 달리다' 춘천연합마라톤 4천833명 출발!…"강촌 부활"연합뉴스 2025.10.03 |
 |
서울 도심 보수단체 집회·행진…여전히 "차이나 아웃"(종합)연합뉴스 2025.10.03 |
![[쇼츠] '하늘을 달리다' 춘천연합마라톤…](https://images-cdn.newspic.kr/thumb1/2025/10/03/7edaf8b9-deae-4409-9990-0ab117f99f65.jpg) |
[쇼츠] '하늘을 달리다' 춘천연합마라톤…"강촌 다시 뜨겁게"연합뉴스 2025.10.03 |
 |
제철 맞아 인기…강화도서 생산하는 '국민 식재료' 사러 관광객 북적위키트리 2025.10.03 |
 |
김제 크레인 제작·설치 공장서 불…인명피해 없어연합뉴스 2025.10.03 |
 |
충북 상반기 하천오염 민원 72건…'유류 유출' 최다연합뉴스 2025.10.03 |
|
충청권 여러 군부대서 식중독 의심신고…장병 190명 증상 호소(종합)연합뉴스 2025.10.03 |
 |
구리도시공사, 신속한 심폐소생술로 승객 생명 구해경기일보 2025.10.03 |
 |
구리남양주교육지원청, 갈매유치원서 어린이 통학안전 캠페인경기일보 2025.10.03 |
 |
김동연, 추석 맞아 문산자유시장 방문 …하반기 통큰세일 내달 22~30일 진행경기일보 2025.10.03 |
 |
아예 멸종된 건데…놀랍게도 복원될 수도 있다는 닭보다 10배 큰 '이 동물'위키트리 2025.10.03 |